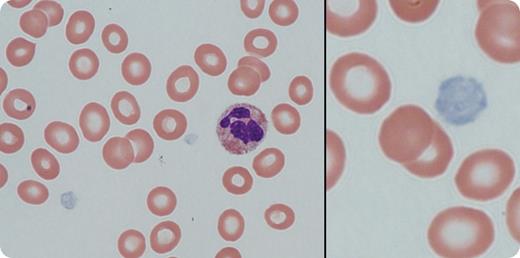
A 7-year-old boy of Pakistani origin was referred for thrombocytopenia and possible IgA deficiency. His medical history was significant for frequent upper respiratory tract infections and otitis media. There was no history of epistaxis, oropharyngeal bleeding, petechiae, bruising, or other bleeding problems. Physical examination was normal with no evidence of hepatosplenomegaly. Laboratory evaluation revealed hemoglobin 129 g/L, white blood cell count 7.4 × 109/L, and platelet count 58 × 109/L. There was no family history of thrombocytopenia or bleeding; both parents (unrelated) and a sibling had normal platelet counts. Peripheral blood film examination (see figure) revealed large pale platelets, suggesting a diagnosis of gray platelet syndrome, which was confirmed by electron microscopy. Next-generation sequencing of platelet RNA demonstrated intron retention in NBEAL2 transcripts. Genomic DNA sequencing confirmed compound heterozygous mutation of NBEAL2, which produces a protein predicted to be involved in megakaryocyte vesicular trafficking. / Autosomal recessive inherited gray platelet syndrome was first described in 1971 by Raccuglia in patients having macrothrombocytopenia and mild to moderate bleeding. Most of the patients later develop splenomegaly and myelofibrosis. The diagnosis of this disorder is first considered by the presence of pale-appearing platelets on a peripheral blood smear. Confirmation is made by electron microscopy that shows an absence of platelet α-granules.

A 7-year-old boy of Pakistani origin was referred for thrombocytopenia and possible IgA deficiency. His medical history was significant for frequent upper respiratory tract infections and otitis media. There was no history of epistaxis, oropharyngeal bleeding, petechiae, bruising, or other bleeding problems. Physical examination was normal with no evidence of hepatosplenomegaly. Laboratory evaluation revealed hemoglobin 129 g/L, white blood cell count 7.4 × 109/L, and platelet count 58 × 109/L. There was no family history of thrombocytopenia or bleeding; both parents (unrelated) and a sibling had normal platelet counts. Peripheral blood film examination (see figure) revealed large pale platelets, suggesting a diagnosis of gray platelet syndrome, which was confirmed by electron microscopy. Next-generation sequencing of platelet RNA demonstrated intron retention in NBEAL2 transcripts. Genomic DNA sequencing confirmed compound heterozygous mutation of NBEAL2, which produces a protein predicted to be involved in megakaryocyte vesicular trafficking.
Autosomal recessive inherited gray platelet syndrome was first described in 1971 by Raccuglia in patients having macrothrombocytopenia and mild to moderate bleeding. Most of the patients later develop splenomegaly and myelofibrosis. The diagnosis of this disorder is first considered by the presence of pale-appearing platelets on a peripheral blood smear. Confirmation is made by electron microscopy that shows an absence of platelet α-granules.
A 7-year-old boy of Pakistani origin was referred for thrombocytopenia and possible IgA deficiency. His medical history was significant for frequent upper respiratory tract infections and otitis media. There was no history of epistaxis, oropharyngeal bleeding, petechiae, bruising, or other bleeding problems. Physical examination was normal with no evidence of hepatosplenomegaly. Laboratory evaluation revealed hemoglobin 129 g/L, white blood cell count 7.4 × 109/L, and platelet count 58 × 109/L. There was no family history of thrombocytopenia or bleeding; both parents (unrelated) and a sibling had normal platelet counts. Peripheral blood film examination (see figure) revealed large pale platelets, suggesting a diagnosis of gray platelet syndrome, which was confirmed by electron microscopy. Next-generation sequencing of platelet RNA demonstrated intron retention in NBEAL2 transcripts. Genomic DNA sequencing confirmed compound heterozygous mutation of NBEAL2, which produces a protein predicted to be involved in megakaryocyte vesicular trafficking.
Autosomal recessive inherited gray platelet syndrome was first described in 1971 by Raccuglia in patients having macrothrombocytopenia and mild to moderate bleeding. Most of the patients later develop splenomegaly and myelofibrosis. The diagnosis of this disorder is first considered by the presence of pale-appearing platelets on a peripheral blood smear. Confirmation is made by electron microscopy that shows an absence of platelet α-granules.
For additional images, visit the ASH IMAGE BANK, a reference and teaching tool that is continually updated with new atlas and case study images. For more information visit http://imagebank.hematology.org.